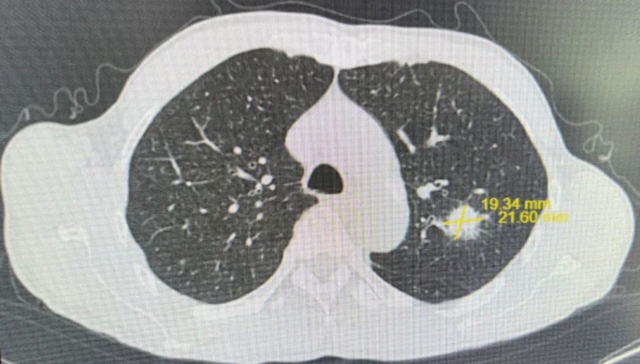
【围观】仅三个月,肿瘤就消失了,癌症有那么可怕吗?(图3) 微信图片_20231026092946.jpg
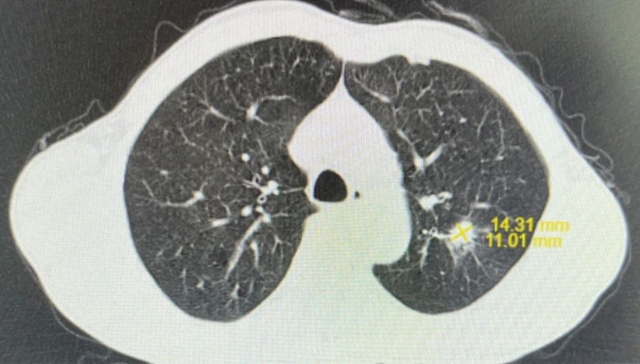
【围观】仅三个月,肿瘤就消失了,癌症有那么可怕吗?(图5) 微信图片_20231026092955.jpg

川南在线 发布时间:2023-10-26
9个月前,65岁的李大叔无意间发现右侧颈部包块,约“鸡蛋”大小,很硬,包块无疼痛,李大叔未予以重视,未到医院进行诊治。此期间,包块逐渐增大。
3月前,包块增大至“鹅蛋”大小,李大叔满面愁容地来到西南医科大学附属中医医院就诊,肿瘤·血液病科医疗组长伍谨林主治医师接诊并完善相关检查后,李大叔大吃一惊。
彩超结果:右侧颈部低回声结节,大小约5*6*5cm;
鼻咽部核磁共振:鼻咽部粘膜明显增厚(右侧为甚),鼻咽腔变窄,符合鼻咽癌变表现,双侧颈部多发淋巴结增大转移,右侧为多;
鼻咽部活检:“鼻咽部”分化型非角化性癌;
肺部CT:左肺上叶尖后段软组织结节,大小约2.1×1.9cm²,边缘见毛刺,结合病史,考虑肺转移可能。
综合检查结果,西医诊断为:鼻咽部恶性肿瘤(分化型非角化性癌)侵及口咽、咽旁间隙伴咽后、颈部转移淋巴结;肺继发恶性肿瘤;中医诊断为鼻咽癌(痰瘀互结)。

伍谨林医疗组长立即在组内做了详细的病例讨论,并邀请了病理科、放射影像科、耳鼻咽喉科等多学科专家行MDT讨论,共同为其制定了中西医结合的治疗方案:西医先予以第一周期GP方案化疗,化疗同时配合中医药化痰消瘀散结、益气扶正等治疗。
治疗后李大叔的颈部包块较前减小,李大叔脸上绽放了久违的笑容,也使得医务人员对接下来的治疗充满了信心。
之后,针对鼻咽部肿瘤予以同步放化疗1周期,在此期间予以靶向治疗;中医予以益气养阴、解毒扶正,外涂院内制剂黄连解毒膏防治放射性皮炎。
经积极治疗后,李大叔颈部包块基本消失,肺部病灶明显缩小,尤其是放疗期间李大叔头颈部放射性皮炎、放射性口咽炎轻微,生存质量高。

治疗3月后,李大叔复查胸部CT与上次比较,肺部结节缩小,大小约1.6×1.3cm²;复查鼻咽部MRI提示:鼻咽部病灶明显缩小,右侧咽旁间隙肿大淋巴结未见显示,颈部双侧淋巴结数量减少、体积缩小。




经过中西医结合规范治疗,李大叔肿瘤明显缩小,现定期于伍谨林主治医师处复诊,予以中药益气养阴扶正、抗肿瘤复发等中药特色治疗。

伍谨林
主治医师
医学硕士
擅长头颈部肿瘤、胸部肿瘤、消化道肿瘤、肉瘤等常见恶性肿瘤的非手术治疗及中医药治疗。
如何治疗鼻咽癌
鼻咽癌大多对放射治疗具有中度敏感性,放射治疗是鼻咽癌的首选治疗方法。但是对于较高分化癌、病程较晚以及放疗后复发的病例,手术切除和化学药物治疗亦属于不可缺少的手段。

放射治疗
放射治疗是鼻咽癌的首选根治性的治疗方案。早期鼻咽癌可经单纯放射治疗治愈,而中晚期鼻咽癌则以放疗联合化疗、靶向治疗、免疫治疗等综合治疗模式为主。5年总生存率高达80%。
化疗
全身性化疗药物抗肿瘤治疗,主要通过化疗物质杀死癌细胞。
靶向治疗
分子靶向治疗是在细胞分子水平上,针对已经明确的致癌位点的治疗,从而阻止肿瘤细胞生长。
手术治疗
对于局部放疗失败或放疗后复发以及颈部淋巴结放疗后残留或者复发的患者,手术切除是鼻咽癌放疗后未得到控制或复发的补救手段。
中医治疗
鼻咽癌主要病机为正气不足、毒热内蕴、痰瘀互结,治疗上要抓住主要矛盾,重视疾病不同阶段的演变规律,辨证施治、对症下药。
中医治疗鼻咽癌总原则是扶正祛邪、减毒增效。在辨证论治基础上,发挥中医药优势,实现中医药与放化疗的相辅相成,从而发挥更好的治疗效应。
患者放疗期间,肿瘤·血液病科使用特色院内制剂黄连解毒膏涂擦患者患处,可有效地防治放射性皮炎,同时降低患者放射性皮炎的西药费用。
鼻咽癌放化疗后调护

膳食
鼻咽癌以热证多见,应用一些清热解毒及养阴之品,如各种鱼类、鸭肉、蛋类、鱼翅、海参、鱼肚等,并应以煲汤、煮、蒸为宜。适当多食梨、番茄、西瓜等瓜果蔬菜,既能清热又可生津,对鼻咽癌放疗患者尤为适宜。
锻炼
茶漱
每次进食后用温茶水漱口,鼓颊与吸允动作交替结合,充分含漱1-3分钟,消除齿缝间的食物残渣,达到洁齿,保持口腔卫生的作用,漱口后20分钟内不能进食和饮水。
叩齿
上下牙齿轻轻叩打或咬牙,每天2-3次,每次100下左右,最后用舌尖舔牙周3-5圈结束。这样做可坚固牙齿,充分锻炼咀嚼肌,预防其纤维化。
咽津
经常做吞咽动作,使津液下咽,可刺激唾液分泌,湿润咽喉部,减轻口舌干燥,并能运动舌头,牙齿及颊部的肌肉,防止口腔功能退化。
气功锻炼
鼻咽癌患者放疗后宜进行气功锻炼,如太极拳等。
肿瘤·血液病科









忠山病区:忠山院区2-4楼
电话:0830-3163725
城北病区:第二住院大楼10、11楼
电话:0830-2512571
(来源:西南医科大学附属中医医院)
编辑:游江
关注川南在线网微信公众号
长按或扫描二维码 ,获取更多最新资讯
其他